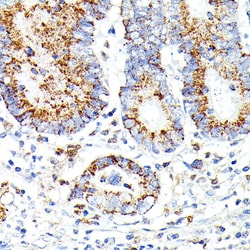
Invitrogen IL13RA2 Polyclonal Antibody 100 &mu;L; Unconjugated:Antibodies,

Learn More
Invitrogen™ IL13RA2 Polyclonal Antibody


Rabbit Polyclonal Antibody
Brand: Invitrogen™ PA596045
Description
Immunogen sequence: DTEIKVNPPQ DFEIVDPGYL GYLYLQWQPP LSLDHFKECT VEYELKYRNI GSETWKTIIT KNLHYKDGFD LNKGIEAKIH TLLPWQCTNG SEVQSSWAET TYWISPQGIP ETKVQDMDCV YYNWQYLLCS WKPGIGVLLD TNYNLFYWYE GLDHALQCVD YIKADGQNIG CRFPYLEASD YKDFYICVNG SSENKPIRSS YFTFQLQNIV KPLPPVYLTF TRESSCEIKL KWSIPLGPIP ARCFDYEIEI REDDTTLVTA TVENETYTLK TTNETRQLCF VVRSKVNIYC SDDGIWSEWS DKQCWEGEDL SKKTLLR; Positive Samples: THP-1, Mouse spleen, Rat thymus, Rat spleen; Cellular Location: Membrane, Single-pass type I membrane protein.
IL13RA2 (interleukin-13 receptor subunit alpha-2) is closely related to IL13RA1, a subuint of the interleukin 13 receptor complex. This protein binds as a monomer to IL13 with high affinity, but lacks cytoplasmic domain, and does not appear to function as a signal mediator.
Specifications
| IL13RA2 | |
| Polyclonal | |
| Unconjugated | |
| IL13RA2 | |
| cancer/testis antigen 19; CD213a2; CT19; IL-13 receptor subunit alpha-2; IL13BP; IL13R; IL-13R; IL-13R subunit alpha-2; IL13RA2; IL-13RA2; IL-13R-alpha-2; interleukin 13 binding protein; interleukin 13 receptor alpha 2; interleukin 13 receptor alpha 2 chain; interleukin 13 receptor alpha chain 2; interleukin 13 receptor subunit alpha 2; interleukin 13 receptor, alpha 2; interleukin-13 receptor subunit alpha-2; interleukin-13 receptor subunit alpha-2-like; interleukin-13-binding protein | |
| Rabbit | |
| Affinity Chromatography | |
| RUO | |
| 16165, 171060, 3598 | |
| -20°C, Avoid Freeze/Thaw Cycles | |
| Liquid |
| ELISA, Immunohistochemistry (Paraffin), Western Blot | |
| 1.76 mg/mL | |
| PBS with 50% glycerol and 0.05% ProClin 300; pH 7.3 | |
| O88786, Q14627, Q8VHK6 | |
| IL13RA2 | |
| Recombinant protein (or fragment). | |
| 100 μL | |
| Primary | |
| Human, Mouse, Rat | |
| Antibody | |
| IgG |
Your input is important to us. Please complete this form to provide feedback related to the content on this product.